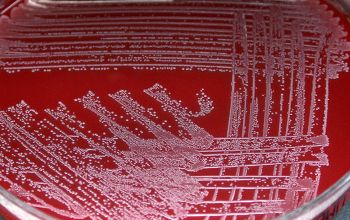

Arcanobacterium haemolyticum
-
General information
Taxonomy
Family: Actinomycetaceae
Formally: Corynebacterium
Natural habitats
The natural habitat is not fully understood, but they are recovered from throat as well as from wound swabs.
Clinical significance
They have been isolated from the throat and wounds and are responsible for 0.5-2.5 % of bacterial pharyngitis, especially among adolescents (15-20 years).
Symptoms may resamble a β-hemolytic streptococci, viral infection or penicilline allergy.
A rash of the chest and of the abdomen, neck or extremities.
They often occurs in polymicrobial infections together with typical respiratory pathogens such as streptococci.
The isolation of classical pathogens from specimens that also contain A. haemolyticum might be in part responsible for the tendency to miss the organism.
-
Gram stain
Gram positive slim, irregular rods,
sometimes with early branching, often located in V-shapes.
Older cells colors uneven, making them look like short chains of streptococci
Broth: more branches visible
Anaerobic environment: cells are longer and slimmer
-
Culture characteristics
-
Facultative anaerobic
5 % CO2 improves the growth
BA: small colonies of 0.5 mm, with a narrow β-hemolytic zone appear after 48 hours.
Agar plates with human/rabbit blood provide larger colonies including β-hemolytic zone.
There are two types of colonies:
1) white, smooth, mucoid colonies usually from wounds
2) gray, dry, friable colonies usually from respiratory
Trueperella pyogenes (Arcanobacterium) looks the same like
A. haemolyticum in Gram stain and colony morphology, but
T. pyogenes is slightly larger and with increased hemolysis
McConkey: no growth
BBAØ: growth
-
-
Characteristics
-
References
James Versalovic et al.(2011) Manual of Clinical Microbiology 10th Edition
Karen C. Carrol et al (2019) Manual of Clinical Microbiology, 12th Edition